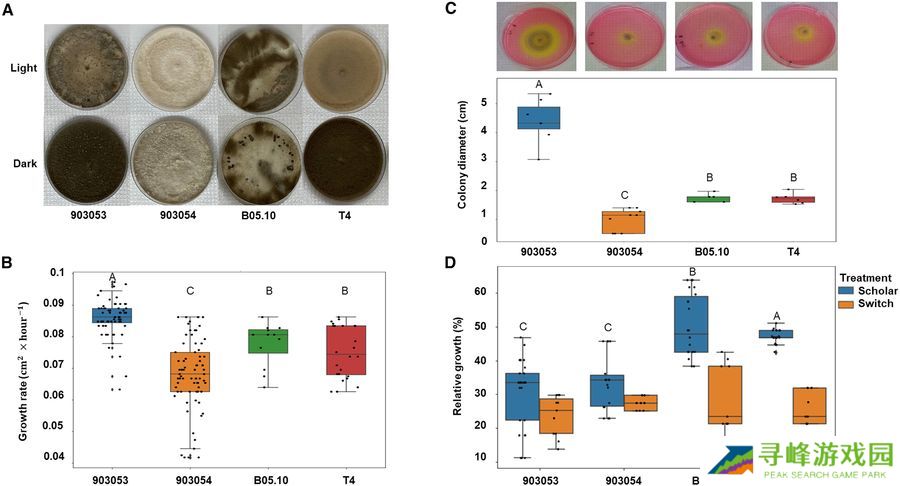

感谢本站网友 小星_14 的线索投递!
本站 7 月 31 日消息,科技媒体 eurekalert 于 7 月 27 日发布博文,报道称以色列研究人员从博物馆藏品中,复活了 80 年前的真菌病原体,发现这些绿色革命前的菌株与现代菌株存在显著差异,揭示了数十年农药使用和集约化农业如何重塑植物病原体。
该研究由 Dagan Sade 博士领导,在 Robert H. Smith 农业、食品与环境学院教授 Gila Kahila 的指导下,与希伯来大学、特拉维夫大学、本-古里安大学以及农业和农村发展部的研究人员合作研究,相关成果发表在《交叉学科》上。

该研究聚焦于 Botrytis cinerea,这是一种广泛存在的植物病原体,可导致 200 多种作物物种发生灰霉病。这种真菌对农业构成了重大威胁,每年导致数十亿美元损失,对食品安全、贸易和环境健康构成挑战。
但是,如果我们复活一个在没有合成肥料和杀菌剂、在绿色革命彻底改变我们种植食物方式之前的真菌,会发生什么呢?
为了找出答案,研究团队复活了自 1940 年代初以来一直在希伯来大学国家自然历史收藏中保存的两个 Botrytis cinerea 菌株 —— 这是在现代农药成为农业标准之前数十年的标本。
这些历史标本经过精心复活,并接受了最先进的分析,包括全基因组测序、转录组学(基因表达分析)和代谢组学(化学指纹分析)。
研究结果令人震惊:历史菌株与现代实验室菌株相比在遗传和行为上存在显著差异。具体包括:杀菌剂抗性迹象减少,这一特征在现代菌株中因化学品的过量使用而变得突出;致病性差异,一些特征表明历史真菌比现代真菌更不专一、攻击性较低;对不同环境条件的适应性,包括 pH 耐受性和宿主特异性。

研究指出,灰霉菌约 80 年的演化反映了人类农业活动对微观生态系统的长期影响。通过比较老菌株与现代菌株,研究人员能够量化人为干预带来的生物学代价,有助于改善植物病害管理、生物多样性保护和推进可持续农业实践。

本站附上参考地址
Reviving 80-year-old fungi offers new clues for sustainable agriculture
From herbarium to life: Implications of reviving historical fungi for modern plant pathology and agriculture